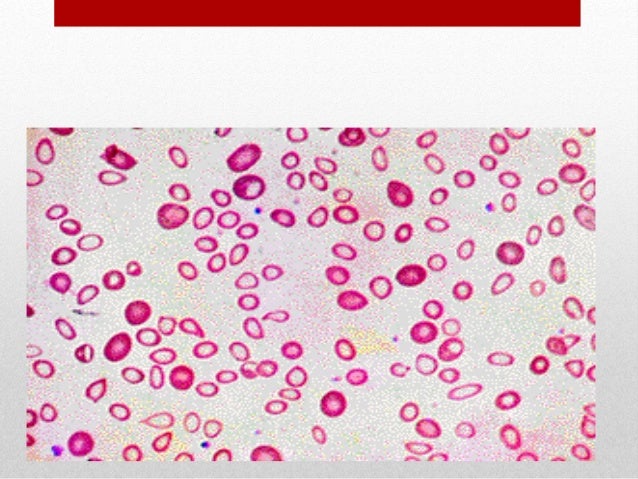

Ubat cacing untuk kanak kanak bawah 2 tahun, ubat cacing, ubat cacing zentel, ubat cacing untuk kanak kanak bawah 2 tahun,

Random Image

Ubat cacing untuk kanak kanak bawah 2 tahun, ubat cacing, ubat cacing zentel, ubat cacing untuk kanak kanak bawah 2 tahun,